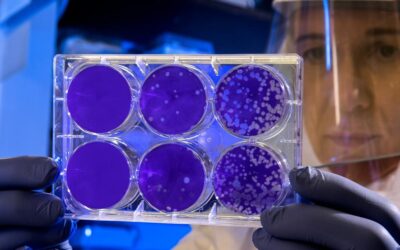
Células de cáncer serían capaces de hibernar «como los osos» para sobrevivir a quimioterapia, según estudio

La inmunidad a la infección por SARS-CoV-2 puede durar al menos seis meses, según un estudio publicado durante este...
¿Cómo evitar la conjuntivitis?
La conjuntivitis es una de las enfermedades más comunes del verano y puede contagiarse al compartir toallas, acudir a...
Otitis: Especialistas advierten infección en aguas estancadas de piscinas inflables
EsSalud advirtió que la permanencia prolongada de niños en piscinas inflables con aguas estancadas podría provocar...
Recuperados de COVID-19 tienen al menos un síntoma por meses
La enfermedad dejó secuelas en al menos el 76% de pacientes, revela investigación científica en China. Siete de cada...
OMS lamenta que 10 países concentren el 95% de vacunas contra COVID-19
Europa tiene que ser solidaria con las vacunas, teniendo en cuenta que hasta ahora el 95% de las dosis han sido...
¿Cuánto ejercicio necesitas realmente?
Ejercitarse de manera intensa no puede ser tan beneficioso. Siempre es bueno establecer rutinas. ¿Alguna vez han...
Células de cáncer serían capaces de hibernar «como los osos» para sobrevivir a quimioterapia, según estudio
En una investigación realizada en Canadá, un grupo de científicos logró descubrir que las células cancerosas tienen la...
El peligro oculto de tomar siestas muy largas, según estudio
Dormir la siesta puede servir para recargar energías, pero un estudio advierte que debería durar menos de una hora,...
COVID-19: Aprende a usar el pulsioxímetro digital
El pulsioxímetro digital se utiliza para medir de forma indirecta la saturación de oxígeno en la sangre. Los valores...
EsSalud advierte que cada vez son más jóvenes los pacientes intubados por COVID-19
El Seguro Social de Salud (EsSalud) advirtió que adultos entre 45 y 55 años están ingresando de emergencia para ser...
Mala calidad de sueño aumenta el riesgo de desarrollar alzhéimer
Dos estudios sugieren un vínculo entre el insomnio y el aumento del riesgo de desarrollar alzhéimer. Las noches en...
Bebés y adultos mayores tienen más riesgo de sufrir insolación
Los bebés, adultos mayores y personas que trabajan al aire libre (policías, comerciantes, deportistas, etc.) tienen...
COVID-19: 7 de cada 10 recuperados tiene al menos un síntoma hasta seis meses después
Más de tres cuartas partes de las personas que fueron hospitalizadas por covid-19 en China siguen sufriendo al menos...
¿Por qué deberías entrenar todos los días a la misma hora?
Informes apuntan que, si se quiere aprovechar al máximo el deporte que se haga, debe realizarse todos los días a la...
¿Control de obesidad revierte la diabetes?
La diabetes tipo 2 es una enfermedad crónica que se da cuando el cuerpo no puede producir suficiente insulina o...
Conoce los 5 tipos de pruebas de detección de COVID-19 disponibles en Piura
Conoce los cinco tipos de pruebas de detección de COVID-19 disponibles en Piura. Ante una posible segunda ola de...
Tumores cerebrales pueden surgir por una lesión mal curada, según estudio
Los tumores cerebrales pueden surgir de una lesión que no se curó adecuadamente, según han descubierto científicos...
Consejos para cuidar los ojos en pandemia
Hay que colocarse adecuadamente la mascarilla y buscar un ambiente iluminado para trabajar usando una computadora. El...
Fumadores ocasionales también pueden sufrir adicción a la nicotina
¡Atención! La adicción a la nicotina puede suponer un problema también para las personas que solo fuman...
¿Qué son los hongos y cómo evitarlos?
Una de cada tres personas tiene este tipo de infección. Evitar la humedad y asearse bien, reducen el riesgo de hongos...
Enfermedad pulmonar crónica de fumadores puede ser mortal frente al covid-19
Essalud advierte que pacientes con EPOC que continúan fumando presentan mayor riesgo de contraer una infección por el...
Minsa: Más peruanos sufren de insomnio a causa del coronavirus
Las cifras de insomnio en la población peruana se han incrementado a causa de la pandemia del coronavirus, lo que...
¿Los ronquidos son señal de algo malo?
Si bien todas las personas roncan de vez en cuando, hay algunas personas para quienes se vuelve un mal crónico que...
En ‘modo positivo’ para recibir el 2021
Para este nuevo año desecha de tu cabeza ideas negativas que a la larga afectarán tu salud mental. La pandemia ha...
Sedentarismo infantil en pandemia aumenta el riesgo de sobrepeso y obesidad
Especialista del Seguro Social de Salud – EsSalud advirtió que el sedentarismo infantil en tiempos de pandemia aumenta...
COVID-19: Embarazadas en tercer trimestre no contagian al recién nacido
Un estudio financiado por los Institutos Nacionales de Salud (NIH) de Estados Unidos concluye que es poco probable que...
Los probióticos podrían ayudar a controlar la obesidad infantil, según nuevo estudio
Más de 340 millones de niños y adolescentes en el mundo tenían sobrepeso o eran obesos para 2016, lo que significa que...
¿Por qué es importante la vitamina D?
La vitamina D es una vitamina que el cuerpo humano es capaz de producir por si solo. Sin embargo puede ser escaso y...
Ruidos de fuegos artificiales afectan a personas vulnerables
Cuidado. Especialistas alertan sobre los daños momentáneos o permanentes que puede ocasionar el uso de la pirotecnia...
¿Cómo mejorar la salud intestinal?
Son muchas las ocasiones en que nos sentimos hinchados, con dolor de estómago, incómodos y atascados, aparentemente...